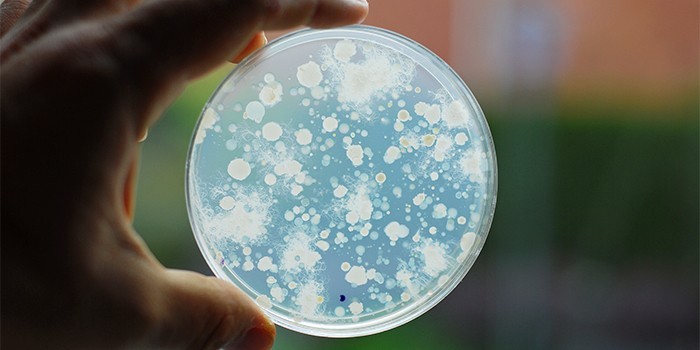
image

Патология представляет собой патологические разрастания эндометрия (железистой ткани матки), распространяющиеся на органы малого таза и другие системы. Женщинам, находящимся в группе риска, необходимо тщательно соблюдать меры профилактики.
Причины эндометриоза у женщин
В настоящее время не выявлено точной причины возникновения эндометриоза у женщин. Существует несколько теорий развития патологии:
- Имплантационная (ретроградной менструации). Согласно этой теории, клетки эндометрия через маточные трубы попадают в брюшную полость. Это происходит при увеличении давления внутри органа. Такой патологический процесс возможен при высокой способности клеток к прилипанию (адгезии) и имплантации в поверхность брюшины, нарушении гормональной регуляции, работы иммунной системы.
- Эндометриальная. Теория предполагает, что причиной патологии являются аборты, диагностические процедуры, операции, нарушающие целостность слизистой оболочки. В результате клетки эндометрия проникают в толщу стенки матки, разрастаются.
- Эмбриональная. Предполагается, что формирование эндометриоза происходит при нарушении развития мочеполовой системы во внутриутробном периоде.
- Метапластическая. Согласно этой теории, клетки некоторых тканей могут трансформироваться в эндометриальные под воздействием некоторых факторов. Такие изменения характерны для плевры, почек, брюшины, лимфатических сосудов.

Факторы риска развития патологии
Существует несколько условий, при которых вероятность развития эндометриоза увеличивается. К факторам риска относят:
- наследственную предрасположенность;
- перенесенные вирусные инфекции;
- частые стрессы;
- нарушения менструального цикла;
- возраст после 30 лет;
- ожирение, нарушения процессов обмена веществ;
- курение;
- длительное использование внутриматочных контрацептивов;
- снижение иммунитета;
- отсутствие овуляции;
- частые операции (выскабливания матки в целях диагностики, по медицинским показаниям, аборты).
Мнение врача:
Профилактика эндометриоза у женщин играет ключевую роль в поддержании их здоровья. Врачи рекомендуют регулярные консультации с гинекологом, особенно при наличии факторов риска, таких как нарушения менструального цикла, гормональный дисбаланс, генетическая предрасположенность. Терапия включает в себя правильное питание, умеренные физические нагрузки, отказ от вредных привычек. Важно также избегать стрессовых ситуаций, которые могут усугубить симптомы заболевания.

Можно ли предотвратить эндометриоз
Поскольку точных причин развития эндометриоза у женщин не выявлено, профилактика заболевания затруднена. Рекомендуемые меры по предотвращению патологии направлены на исключение или ограничение факторов риска. Также проводятся гинекологические осмотры для профилактики и своевременного обнаружения проявлений болезни.

Статьи по теме
- Последствия эндометриоза у женщин – риск развития онкологии и другие патологии
- Признаки эндометриоза у женщин – первые проявления заболевания и диагностика
- Причины эндометриоза – симптомы и фазы развития заболевания, способы лечения
Интересные факты
Факт 1: Эндометриоз может быть бессимптомным. Это означает, что женщина может иметь эндометриоз и не знать об этом. Это потому что эндометриоз может не вызывать никаких симптомов или вызвать легкие симптомы, которые можно легко пропустить.
Факт 2: Эндометриоз может привести к бесплодию. Это потому что эндометриоз может повредить фаллопиевые трубы и яичники. Это может затруднить женщине забеременеть естественным путем.
Факт 3: Существуют различные факторы риска эндометриоза. К ним относятся:
• Наследственность
• Менструальные циклы, которые короче 27 дней
• Отсутствие родов
• Поздние менопаузы
• Избыточный вес или ожирение
• Использование внутриматочной спирали (ВМС)

Методы снижения риска развития эндометриоза
Соблюдение правил профилактики не дает полной гарантии, что патологии удастся избежать. Существуют меры, направленные на снижение риска возникновения и развития заболевания:
- Укрепление иммунитета.
- Избегание частых стрессов.
- Ограничение или отказ от использования тампонов.
- Исключение половых контактов во время менструации.
- Регулярное посещение гинеколога (1-2 раза/год).
- Отказ от курения.
- Контроль продолжительности, регулярности, обильности месячных.
- Отказ от абортов, минимизация оперативных вмешательств в области репродуктивной системы.
- Профилактика, своевременное лечение гинекологических заболеваний.
- Контроль пребывания на солнце.
- Нормализация режима дня и питания.
- Снижение тяжести физических нагрузок.
- Ограничение или исключение применения внутриматочных контрацептивов.

Профилактические осмотры
Профилактика эндометриоза матки заключается в регулярном проведении осмотров у гинеколога. Посещать врача рекомендуется не реже 1 раза в полгода, если у пациентки повышена вероятность развития патологии.
К группе риска относятся:
- девушки, подростки с болезненными, обильными, длительными, нерегулярными менструациями;
- женщины, имеющие в анамнезе тяжелые, осложненные гинекологические заболевания, расстройства гормонального баланса;
- пациентки, перенесшие операции на органах малого таза;
- женщины, использующие внутриматочную контрацепцию.
Своевременное лечение заболеваний
Одной из причин появления эндометриоза являются заболевания вирусного и бактериального происхождения. При отсутствии адекватного лечения инфекции принимают хроническую форму и начинают распространяться. Чтобы обеспечить профилактику образования у женщин эндометриоза, рекомендуется проводить своевременную терапию патологий, вызванных следующими микроорганизмами:
- хламидиями;
- кишечной палочкой;
- клебсиеллой;
- стрептококками;
- дифтерийной палочкой;
- протеем;
- энтеробактерией;
- микоплазмой;
- туберкулезной микобактерией.
Ограничение самолечения
Эндометриоз при отсутствии правильного лечения может вызвать тяжелые осложнения. Терапию должен назначать только специалист, принимая во внимание индивидуальные особенности пациентки, стадию развития болезни. При эндометриозе запрещено прибегать к самолечению, чтобы обеспечить профилактику негативных последствий. При обнаружении признаков заболевания необходимо срочно обратиться к врачу. Выделяют следующие характерные проявления патологии:
- болевые ощущения в области таза, мажущие выделения темного цвета, возникающие перед менструацией;
- дисменорея/меноррагия (болезненные/обильные, продолжительные месячные);
- постгеморрагическая анемия (слабость, утомляемость, сонливость, головокружение, желтушность или бледность кожных покровов во время менструации).
Опыт других людей
Профилактика эндометриоза у женщин играет важную роль в поддержании здоровья. Меры терапии включают в себя регулярные консультации у гинеколога, соблюдение здорового образа жизни и правильное питание. Факторы риска включают генетическую предрасположенность, нарушения гормонального баланса и неправильное лечение воспалительных заболеваний органов малого таза. Люди отмечают, что осознанность и регулярное медицинское наблюдение помогают предотвратить развитие этого заболевания.
Видео
Внимание!
Информация, представленная в статье, носит ознакомительный характер. Материалы статьи не призывают к самостоятельному лечению. Только квалифицированный врач может поставить диагноз и дать рекомендации по лечению, исходя из индивидуальных особенностей конкретного пациента.
Частые вопросы
Что делать для профилактики эндометриоза?
В настоящее время не существует каких-либо известных способов профилактики эндометриоза.
Как лечится эндометриоз у женщины?
При выявлении патологии назначают лечение гормональными препаратами. Эндометриоз шейки матки. Возникают кровянистые выделения в середине цикла, повышенная болезненность в период менструаций. При подтверждении диагноза врач прописывает лечение гормональными препаратами и прижигание очагов разрастания эндометрия.
Чем лечиться при эндометриозе?
Эндометриоз в основном лечится лапароскопическим доступом, вплоть до распространенных форм – ретроцервикального эндометриоза с вовлечением кишечника, эндометриоза мочевого пузыря.
Как бороться с эндометриозом?
При средней и тяжелой стадиях эндометриоза рекомендуется прибегать к органосохраняющему хирургическому лечению с удалением очагов. Лечение всесторонне нацелено на резекцию гетеротопий в пораженных органокомплексах, резекцию эндометриоидных кист в яичниках, а также рассекание спаек.
Полезные советы
СОВЕТ №1
Регулярно проходите осмотр у гинеколога и следите за своим здоровьем. Раннее выявление эндометриоза позволяет своевременно начать лечение и предотвратить развитие осложнений.
СОВЕТ №2
Поддерживайте здоровый образ жизни: занимайтесь физическими упражнениями, правильно питайтесь, избегайте стрессов и негативных эмоций. Это поможет снизить риск возникновения эндометриоза.
СОВЕТ №3
Обратите внимание на свои гормональные изменения и обсудите их с врачом. Нерегулярные менструации, болезненные месячные, боли во время полового акта могут быть признаками эндометриоза, поэтому важно не игнорировать подобные симптомы.









